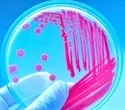

When parts of the liver are removed, the body can regenerate the tissue that was lost. The success of this process, according to a team of researchers at the Technical University of Munich (TUM), is heavily reliant on gut bacteria. The study’s findings may aid in improving the prognosis following liver surgery in cases of liver cancer and other diseases.
Unlike the heart, the human liver has an amazing ability to regenerate. The underlying biological mechanisms demonstrate the role of our gut bacteria in processes occurring in other organs. This is demonstrated in a new study conducted by an interdisciplinary team from TUM University Hospital Klinikum rechts der Isar and TUM School of Medicine.
“However, the medication alters the microbiome’s composition: the remaining bacteria species produce significantly fewer short-chain fatty acids.” The microbiome usually recovers within a few weeks of receiving antibiotics. The current study found that liver regeneration occurred in antibiotic-treated animals, but with a significant delay. There was no regeneration in mice lacking gut bacteria. The researchers were able to stimulate liver regeneration, however, by administering a precisely defined “microbiome starter set.”